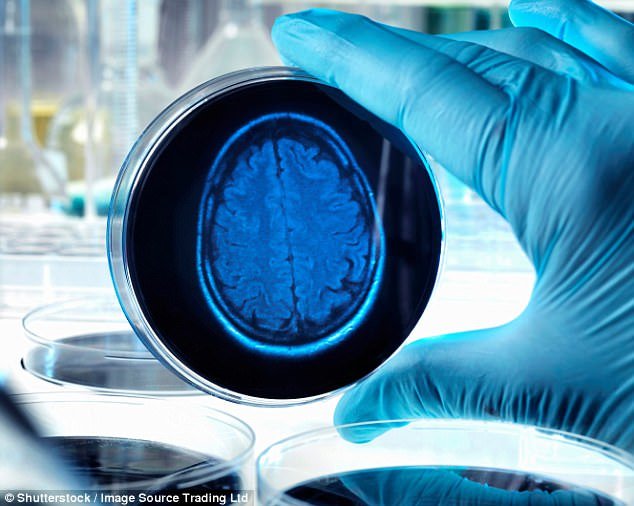

به گزارش هوشمند نیوز، مطالعه سازمان جهانی بهداشت (WHO) نشان میدهد که جمعیت دنیا در سالهای آتی با رشد سریع ابتلا به زوال عقل روبرو خواهد بود و این تحقیق نتیجه گرفته است که تعداد بیماران درگیر دمانس در سال ۲۰۳۰ میلادی دستکم ۴۰ درصد بیشتر از میزان کنونی میشود.
مبنای این نتیجهگیری، پیرتر شدن هر چه بیشتر شهروندان و عدم آمادگی اکثر کشورها برای مواجهه با کهنسالی و پیامدها و عوارض این دوران عمر است.
بنابر اعلام سازمان ملل بیش از ۵۵ میلیون نفر در سراسر جهان با زوال عقل زندگی میکنند.
تدروس آدهانوم، دبیرکل سازمان جهانی بهداشت گفته است که باید برای نگهداری، مراقبت و حمایت از افراد مبتلا به دمانس مجهز بود و آنها و اطرافیانشان را به حال خود رها نکرد.
وی با تمجید از استراتژی دولت آلمان برای پشتیبانی و پرستاری از مبتلایان به این عارضه تاکید کرده است: هدف همه کشورها باید این باشد که منزلت سالخوردگان مبتلا به زوال عقل حفظ شود و آنها به حاشیه اجتماع رانده نشوند.
همچنین یک کارشناس سازمان جهانی بهداشت در زمان ارائه نتایج پژوهش این نهاد یادآور شد که رعایت مجموعهای از ساز و کارها میتواند نرخ ابتلا به دمانس را به طرز قابل توجهی کاهش دهد. سبک زندگی سالم، ارتباطات اجتماعی خلاق، تعاملات عاطفی و آموزش و سواد مناسب، در پیشگیری از ابتلای سالخوردگان به زوال عقل تاثیر قاطع دارند.
به گزارش دویچه وله، دمانس یا زوال عقل با اختلال در حافظه، تغییرات رفتاری و شخصیتی، روانپریشی یا زبانپریشی همراه است. کهنسالان مبتلا، خلق و خوی ناپایدار دارند. آنها به تناوب دچار افسردگی و اضطراب، توهم و خیالات و هذیان میشوند. برخی بدون عامل محرک بیرونی، گاه به شدت میخندند یا گریه میکنند و گروهی نیز مهارتهای کلامی و زبانی را از دست میدهند و در بیان مقصود، وا میمانند.
دمانس می تواند در اثر عوامل مختلفی از جمله اختلالات تیروئید، کمبود ویتامین، عوارض جانبی داروها، افسردگی، اضطراب، عفونتها، سکتههای مغزی، پارکینسون و سایر مشکلات پزشکی و سلامتی ایجاد شود. این اختلال عموما با آلزایمر یکسان گرفته میشود در حالی که آلزایمر زیر مجموعهای از این سندرم است. بین۶۰ تا۸۰ درصد از کل تشخیصهای دمانس به آلزایمر (فراموشی یا نسیان) ختم میشود.
انتهای پیام

آموزش مجازی مدیریت عالی و حرفه ای کسب و کار DBA








ارسال نظر شما
مجموع نظرات : 0 در انتظار بررسی : 0 انتشار یافته : 0